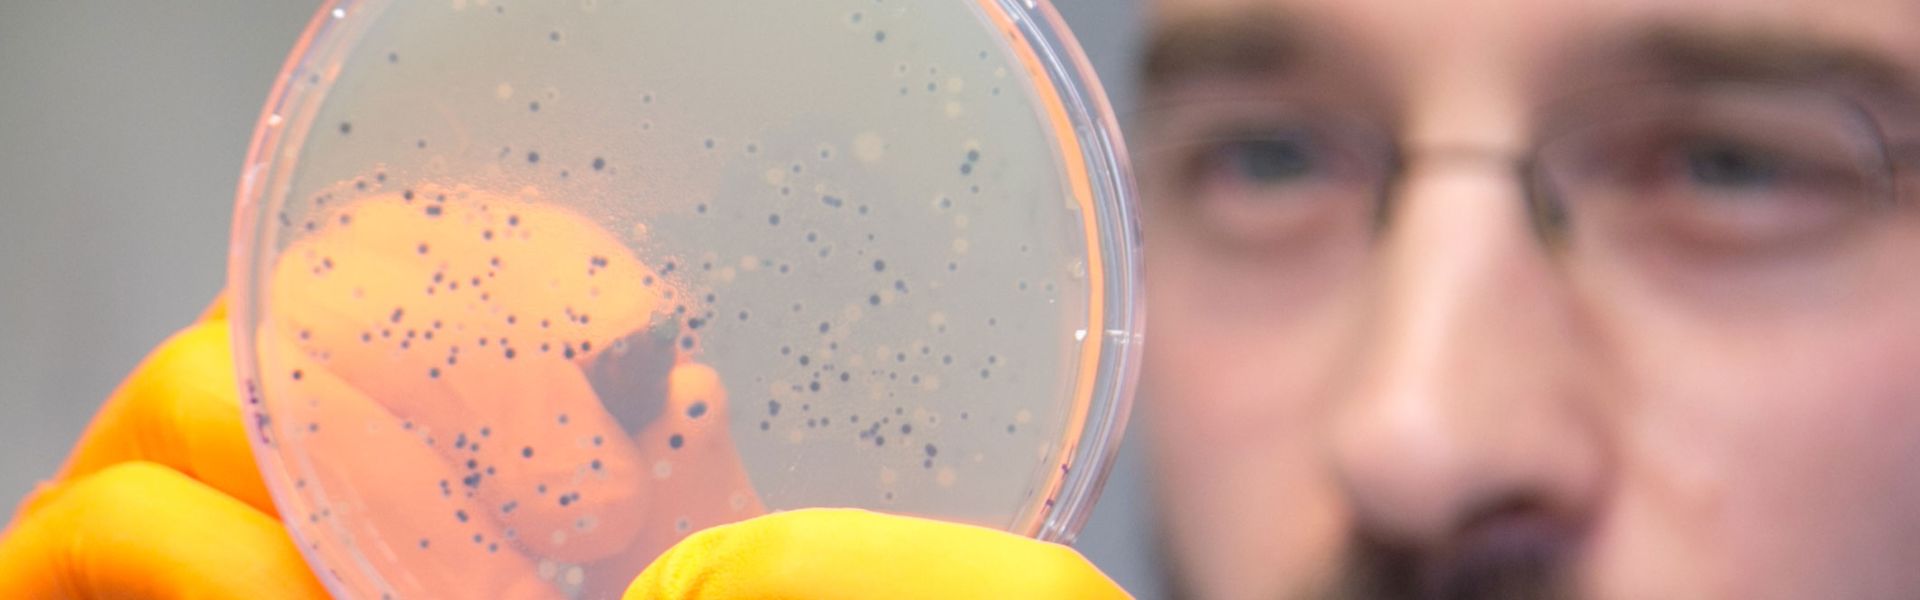

L’Anses, l’EnvA et INRAE renouvellent deux unités mixtes sur les maladies animales
Les deux unités rassemblent des personnels de l’Agence nationale de sécurité sanitaire de l’alimentation, de l’environnement et du travail (Anses), l’École nationale vétérinaire d’Alfort (EnvA), ainsi que de l’Institut national de recherche pour l’agriculture, l’alimentation et l’environnement (INRAE). Elles sont hébergées au sein du bâtiment du laboratoire de santé animale de l’Anses, à Maisons-Alfort. Suite à l’évaluation des unités par le Haut Conseil de l'évaluation de la recherche et de l'enseignement supérieur (HCERES) en 2018 et aux avis positifs des conseils scientifiques des tutelles, les conventions des UMR ont été renouvelées. Les équipes, qui rassemblent plus de 90 techniciens, ingénieurs scientifiques, doctorants et post-doctorants, vont ainsi pouvoir poursuivre des collaborations engagées depuis une vingtaine d’année.
L’unité Bipar
Les activités de l’UMR BIPAR, créée en 1999, sont centrées d’une part sur l'étude des interactions entre hôtes et agents pathogènes, avec pour modèles les vecteurs (tiques, moustiques) et les agents pathogènes qu’ils transmettent (bactéries, parasites et virus) ; et d’autre part, sur les parasites d’origine animale transmis via les aliments. Y sont développées des recherches fondamentales et appliquées, pour une meilleure compréhension de ces interactions, en prenant en compte les niveaux moléculaire, cellulaire et tissulaire, de même que l’hôte et les écosystèmes, dont les microbiotes des hôtes vertébrés et invertébrés. Les recherches portent également sur la circulation de ces agents pathogènes, les stratégies de lutte innovantes vis-à-vis des tiques, des agents pathogènes vectorisés par les arthropodes et des parasites zoonotiques transmis par les aliments : amélioration de la détection et de la surveillance, stratégies vaccinales “universelles”, alternatives “écologiques” aux traitements antiparasitaires et aux acaricides… Cette UMR héberge le centre collaborateur international de l’Organisation mondiale de la santé animale (OIE) et le laboratoire national de référence sur les parasites zoonotiques transmis par les aliments. Entre 2016 et 2020, l’unité a publié 257 articles scientifiques.
L’unité de Virologie
Les activités de l’UMR Virologie, créée en 2002, sont centrées sur les viroses animales à risque de transmission à l’homme et/ou d’émergence. Sont ainsi développées des méthodes de diagnostic optimisées pour la surveillance épidémiologique et l’étude de la variabilité des souches virales, ainsi que des recherches sur la physiopathologie des infections animales, dont certaines d’entre elles centrées sur les risques de transmission entre espèces, particulièrement de l’animal à l’Homme. Enfin, de nouvelles approches de contrôle et de prévention des infections virales sont étudiées. L’UMR mène aussi des travaux de recherche sur les coronavirus, dont le SARS-Cov-2, en particulier sur les animaux de compagnie. Elle héberge également des laboratoires de référence européens ou internationaux, sur la fièvre aphteuse (laboratoire de référence pour l’Union européenne, l’OIE et la FAO), la maladie hémorragique (laboratoire de référence pour l’OIE) ou les maladies équines (laboratoire de référence pour l’Union européenne), mais aussi de nombreux mandats de laboratoires nationaux de référence (fièvre catarrhale ovine, West Nile, peste équine...). Entre 2016 et 2020, l’unité a publié 177 publications dans des revues internationales à comité de lecture.


